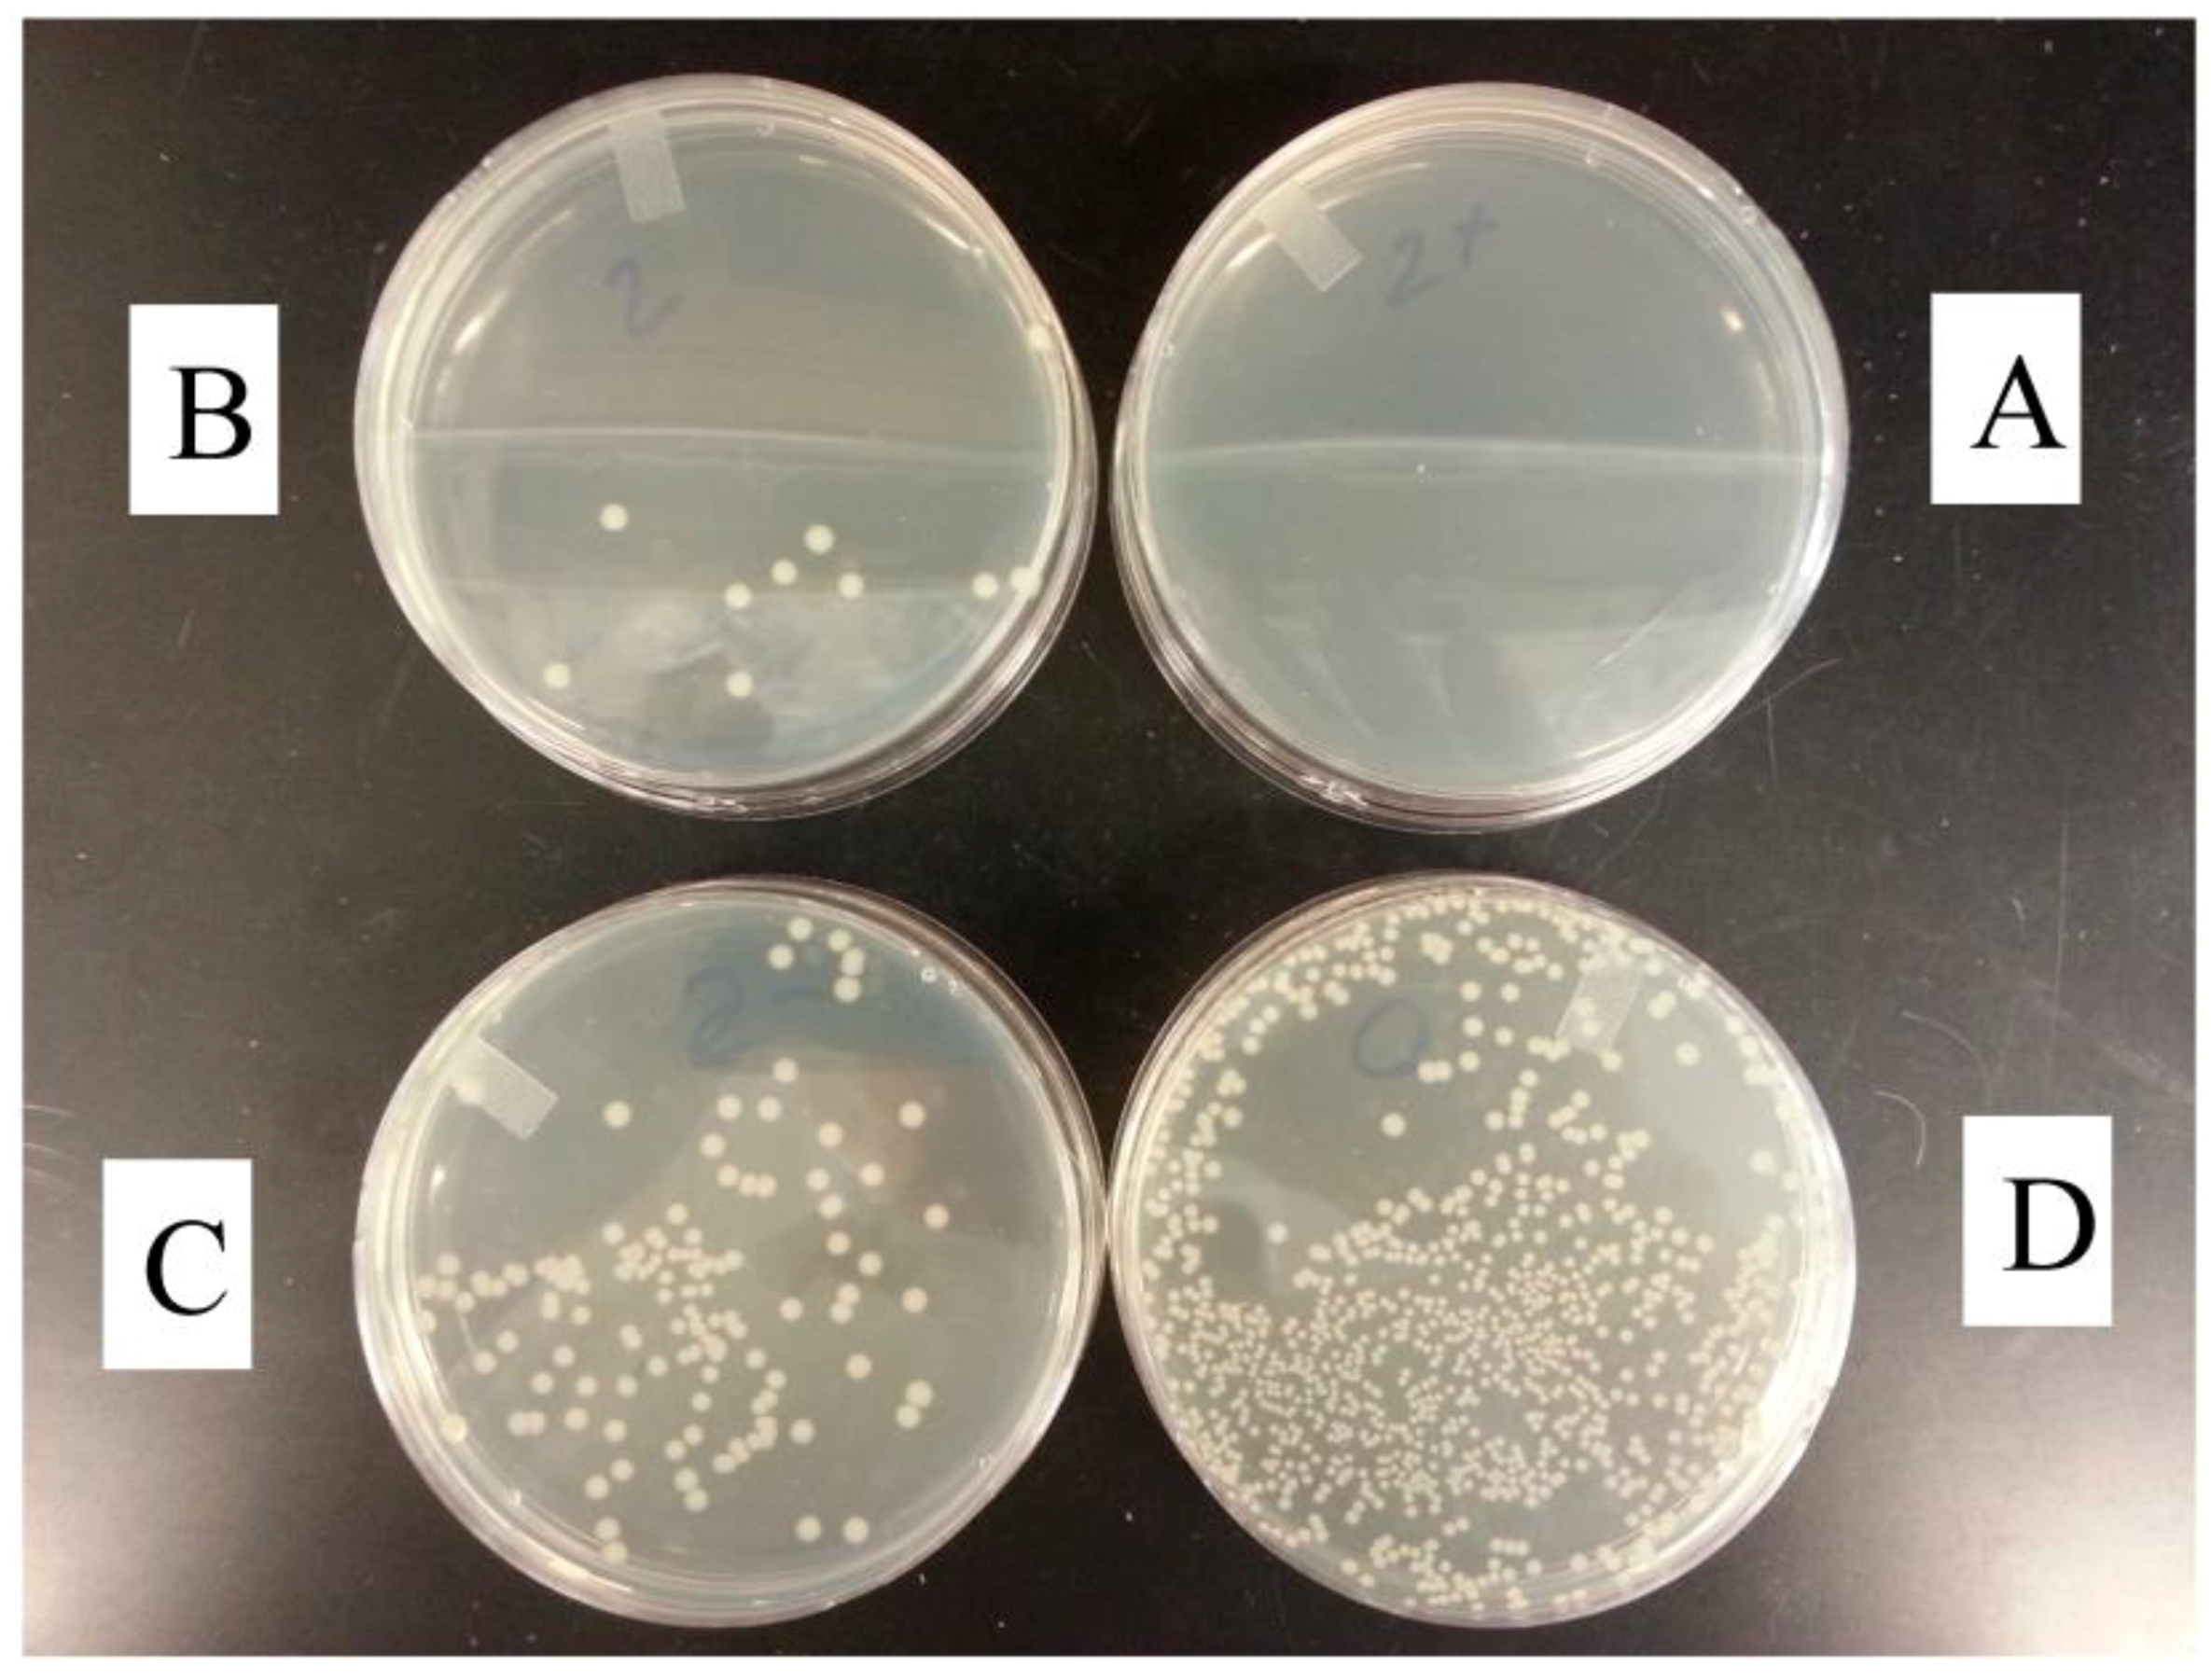
Coatings 08 00041 g007 Coatings 08 00041 g007

Abstract
Fruit and vegetable containers with microbe-free surfaces can be made by coating with titanium dioxide (TiO2) particles or nonmetal (C, N, B, F) doped-TiO2 particles, using wear resistant polymers, such as zein, and paint, as the binders and to form a continuous binding phase. The doped-TiO2 powders absorb visible light radiation, and thus possess a higher antibacterial effect than non-modified TiO2 particles in environmental conditions. The study also presents a double-layer coating to use less TiO2 particles in coating, while achieving higher antimicrobial activity. Containers with microbe-free surfaces can stop cross-contamination from infected workers or spoiled/decayed/contaminated fruits or vegetables, and thus are expected to be able to reduce the risk from microbiological contamination of fruits and vegetables during harvest in fields, and postharvest storage or transportation.
1. Introduction
The fruit agribusiness contributes more than $9 billion annually to the US economy. About 59% of apple and 37% of other non-citrus fruits (such as peach, plum, grape, and cherry, etc.) are consumed by Americans without processing [1]. Eating fresh produce improves quality of life, and fresh fruits and vegetables are important components of a healthy and balanced diet to protect from and fight against a wide range of illnesses, such as diabetes, cancers, high blood pressure, obesity, and cardiovascular diseases. With an increase in the awareness of advantages of fresh foods over processed foods, and through the encouragement of government health agencies and social organizations, the consumption of fresh fruits and raw vegetables has increased in industrial countries and post-industrial countries [2,3]. Meanwhile, the risk of digestive diseases associated with the consumption of produce has also increased [4,5].
Fruit and vegetable contamination can occur in the field or at the postharvest stage. Foodborne pathogens can establish themselves on growing fruits and vegetables from contaminated irrigation water, flies, insects, and soil, or from raw animal manure, sewage, etc. The contaminants can be amplified by the proliferation of the pathogens, or by cross-contamination from infected workers, agricultural materials, or equipment used during harvest and storage, such as containers or shelves [6,7,8]. Containers are used for the collection of fruits and vegetables in fields, transportation, and storage in warehouses and retail rooms. Containers and shelves, either made from cellulosic materials (such as cardboards, baskets, and boxes from bamboo or wood), plastics, or metals, seldom are disinfected or rarely have self-sterilizing functions. They may provide an additional route for transmission (cross-contamination) of pathogens and spoilage organisms once they are contaminated.
Titanium dioxide (TiO2) has a strong killing effect on all kinds of bacteria under UV irradiation, while metal (Cu, Co, Ni, Cr, Mn, Mo, Nb, V, Fe, Ru, Au, Ag, Pt)-doped-TiO2 and nonmetal (N, S, C, B, P, I, F)-doped-TiO2 exhibits high antibacterial activity, even under visible light [9,10,11,12,13,14]. Due to their chemical stability, non-toxicity, and capacity to be repeatedly used without losing activity, these inorganic compounds have demonstrated usefulness as disinfection or sterilization reagents for water and air purification, self-clean solid surfaces, and food protection.
We present here a double-layer coating consisting of a binding phase to cover the solid surfaces with a topping dress of TiO2 or doped-TiO2 particles. Both of the coating materials were tested for antibacterial activity under UV and visible light radiation, and for durability.
2. Materials and Methods
2.1. Materials
TiO2 particles (rutile, particle size <5 µm; 99.9%), tetraethyl ammonium tetra-fluoroborate [(CH3CH2)4NBF4, TEATFB, 99%], Zein (95%), and ethanol (200 proof) were purchased from Sigma-Aldrich-Fluka (St Louis, MO, USA). Petri dish was from VWR (85 × 10 mm, D × H; West Chester, PA, USA). Paint (KILZ Latex 2®; Masterchem Industries, LLC, Imperial, MO, USA) was purchased from a local HomeDepot store (Wyncote, PA, USA).
Escherichia coli O157:H7 Oklahoma was obtained from the culture collection of the U.S. Department of Agriculture, Agricultural Research Service, Eastern Regional Research Center (Wyndmoor, PA, USA). Tryptic soy broth (TSB) was from Remel, Inc. (Lenexa, KS, USA). Tryptic Soy Agar (TSA) was from Difco/Becton Dickinson (Sparks, MD, USA). Butterfield’s phosphate buffer (pH 7.2) was from Hardy Diagnostics (Santa Maria, CA, USA). Deionized (D.I.) water was prepared by ion exchange (Millipore; Billerica, MA, USA).
2.2. Preparation and Characterization of Doped-TiO2 Particles
C, N, B, F-codoped TiO2 particles were prepared as described by Pelaez and Im et al. [10,15]. Briefly, TiO2 powders and TEATFB were mixed at an appropriated ratio and then dried at 110 °C followed by calcination at 600 °C for 2 h under vacuum at the heating rate of 10 °C/min. The resultant powders were characterized for the element concentration and the electronic state of the elements of the materials using an X-Ray photoelectron spectrometer (K-AlphaTM + XPS; ThermoFisher Scientific, Waltham, MA, USA).
2.3. Coating Preparation
Single-layer coating and double-layer coating were prepared in the present study (Figure 1). Zein and commercially available paint were chose as binders. Zein has demonstrated the properties that are necessary to form tough, glossy, hydrophobic, greaseproof coatings that were resistant to microbial attack [16], which were found to be useful in a variety of applications in bioplastics, coating and adhesive materials, laminated board and substitutes for shellac, carriers of bioactives, and pharmaceuticals [17,18,19,20,21,22]. Using zein as a binder, the coating materials were made by mixing TiO2 or doped-TiO2 in zein/ethanol solution (85% ethanol; zein content, 2.5%, w/v). Briefly, 25, 50, or 250 mg TiO2 or doped-TiO2 powders were dispersed in 100 mL of zein/ethanol solution, in which the ratios of TiO2/zein were 1, 2, and 10 wt %, respectively.

Figure 1.
Preparation of single and double layer coating.
For single-layer coating, 10 mL of each TiO2/zein solution was evenly distributed across a petri dish followed by being air-dried on bench at room temperature. Petri dish coated with 10 mL zein solution was also prepared.
For double-layer TiO2/zein coating, 8 mL of zein solutions were coated on the surface of a petri dish to form first layer, when the first layer was 80% dried (about 3 h), 2 mL of 10% TiO2/zein or doped-TiO2/zein suspension were spread on the surfaces of the first zein layer to form the second layer.
To test the durability of coating, coating layers were made on metal plates (D × H, 25 × 2 mm; 1.5 mL for each), using the mixture of TiO2 particles (6%) with KILZ Latex. The paint has been used popularly in the decoration and protection of house, furniture, automobile, ship, and many others that may contact with air, water, foods, and hazards, etc. The painting was firmly adhered to material surfaces after drying. Based on information we have so far, no findings of residual KILZ Latex in food have been reported.
2.4. Antimicrobial Activity Test
Fluorescent light (FL) has a broad range of wavelength that covers UV wave length (300–380 nm) and visible light length (400–800 nm). A fluorescent light installed inside of biohood (40 W, 80 cm above the samples) was used for light irradiation. The illumination density was 11 μmol/s∙m2, as measured by a photometer with Quantum sensor (Li-COR, Lincoln, NE, USA).
The tests were carried out as reported previously [23]. Briefly, prior to the inoculum preparation, E. coli O157:H7 cells were grown in TSB aerobically at 37 °C for 16–18 h. Serial 10-fold dilutions were performed in sterile 0.1% peptone water and inoculated into TSB so as to achieve a population of ca. 4 log colony forming unit (CFU/mL).
5 mL of inoculum was evenly distributed on each coated petri dish, which was enough to cover the surface of the petri dish. Petri dishes without any coating served as controls. Samples were evaluated in three different ways: under FL irradiation for 18 h, under FL irradiation for 15 h followed by placing in dark for 3 h, and under FL irradiation for 3 h followed by placing in dark for 15 h. Specimens, 100 µL of the inoculated TSB in petri dishes, were sampled at hour 3 of the treatment and at the end of experiment (18 h), which was followed by a set of dilution with sterile Butterfield’s phosphate buffer (pH 7.2), surface plated (100 µL per plate and three plates per dilution) onto TSA. Plates were incubated at 37 °C for 24 h before counting CFU. After first sampling, inoculum left on each petri dish was decanted and each petri dish was washed with 10 mL sterile water once, and placed in biohood with fan on for 10 min. Then each dish was poured with 10 mL TSA (50 °C) and incubated at 37 °C for 24 h. Each experiment was conducted in triplicate.
2.5. Durability of TiO2 Coating
The durability of TiO2 coatings was examined using metal disks coated with TiO2/paint formulations. Each coated disk (there were four disks for each coating) was placed in a 3.0 L beaker with 2.0 L water and stirred at 1000 rpm for 1 min at room temperature with the aid of mechanical stirring (Cole-Parmer digital mixer; Cole-Parmer, Vernon Hills, IL, USA). The distance from the tip of the stirrer to the bottom of the beaker was 10 cm. The disks were washed up to 5 times to simulate the repeated use of a food container. The metal disks were moved out from the water and air-dried, and submitted to UV irradiation for 10 min to eliminate possible microbial contamination. The disks thus treated were surface-inoculated with 50 µL of E. coli inoculum. The inoculated disks were placed in biohood under regular fluorescent lamp as described above for 3 or 18 h. At 3 or 18 h, each disk was swept with a wet cotton tip across the entire sample surface in three different directions (0°, 45°, and 90°), put the swab tip off into a test tube containing 10 mL of peptone water, and vortexed in the tube for 1 min. Specimens were serially diluted and surface plated onto TSA. Plates were incubated at 37 °C for 24 h before counting CFU.
2.6. Statistical Analysis
Antimicrobial experiments were conducted in triplicate. Data points were expressed as the mean ± standard deviation. Data were analyzed using analysis of variance from SAS version 9.1 software (SAS Institute, Cary, NC, USA). Duncan’s multiple range tests were used to determine the significant difference of mean values. Unless stated otherwise, significance was expressed at 5% level.
3. Results and Discussion
3.1. Doped-TiO2 Preparation
The results of elemental analysis of pure and doped-TiO2 powders were shown in Table 1. In contrast to the non-treated TiO2 powders, the non-metal elements of boron, carbon, nitrogen, and fluorine were detected with the doped samples. The concentrations of the 4 elements in the prepared samples reduced in the sequence of C > F > N >B, which matches the order in the starting material TEATFB. In a previous publication [15], Lee et al. reported the order of C > B > F > N found in doped-TiO2 powders that were prepared by the same method as ours. The authors claimed that the volatilization of F and N during calcination was the cause of the reduction of the amounts measured for F and N. However, we found it only occurred when the calcination temperature up to 1000 °C.

Table 1.
Atomic concentrations (%).
The XPS spectra of the Ti 2p levels of pure TiO2 and doped-TiO2 were shown in Figure 2. The binding energy of the core level in doped sample indicated the successful incorporation of dopants into the lattice, confirming the results shown in Table 1. We measured the N 1s XPS spectra of the prepared codoped-TiO2 samples. A significant peak at around 400 eV was recorded (Figure 3). This finding is consistent with that reported previously, where peaks at around 400 eV were assigned to N 1s for doped-TiO2 powders prepared from TiO2 and TEATFB and for N-doped anatase TiO2 made by the atmospheric-pressure plasma-enhanced nanoparticles synthesis (APPENS) process operated under normal temperature [24]. We also measured the 1s XPS spectra of C, B, and F in the prepared codoped-TiO2 samples, recorded a peak of 285.6 eV for C–Ti, a peak at 191.7 eV for B–Ti, and a peak around 684.5 eV for F–Ti, as well as another peak of 685 eV in the “shoulder” of asymmetrical line for F (standing for F–Ti–O bond). These data were very close to that shown in [15], where 402 eV was assigned to N–Ti, 191 and 187.5 eV to B–Ti, 285 eV to C–Ti, and 685 eV to F–Ti. Similar results were also published by other laboratories [24,25,26,27,28]. By further measuring the ultraviolet-diffuse reflectance spectra (data not shown), it is easy to calculate the minimum energy required to activate the electron in the doped-TiO2 samples that fell into the range of 2.98–3.06 eV, which is less than 3.2 eV for TiO2. This reduction can be attributed to the charge-transfer transition between the dopants and the TiO2 conduction or valence band, as has been suggested [29].

Figure 2.
Ti 2p XPS spectra of doped and non-treated TiO2 samples.

Figure 3.
XPS spectrum of N 1s within C, F, N, B-codoped-TiO2 sample.
3.2. Microbe-Free Surfaces
In the present study, zein and paint were used as binders to form thin films containing TiO2 or doped-TiO2 powders for surface coating. First, we examined the morphology of obtained films; then, we investigated their antimicrobial activities.
Figure 4 shows the surface morphology of TiO2 powders, C, N, B, F-doped-TiO2 powders, neat zein films, single-layer zein films with of TiO2 powders 2% and 10%, double-layer zein coating with 8 mL neat zein in the bottom, and 2 mL 10% TiO2 particles on the top. The thermal treatment process of TiO2 with (CH3CH2)4NBF4 (Figure 4A,a) at 600 °C slightly changed the appearance of TiO2 particles (Figure 4B,b), but the particle size remained at the same level. The surfaces of neat zein film appeared as a glossy and uniform material without pores (Figure 4C,c). The incorporation of TiO2 particles resulted in a rough morphology (Figure 4D–F,d–f); TiO2 particles were randomly distributed within the matrix phase. The number of particles in a defined area increased with the increase in TiO2 content. Both samples of E and F had similar morphologies, showing similar TiO2 content on their surfaces.

Figure 4.
SEM topography of TiO2 (A,a), doped-TiO2 powders (B,b), neat zein films (C,c), single-layered zein films incorporated with doped-TiO2 powders at 2% (D,d) and 10% (E,e), and double-layered film containing doped-TiO2 powders of 2%. Field width: 5.5 mm (A–F) and 275 μm (a–f).
The antibacterial activity of zein/TiO2 films was first evaluated by measuring the populations of Escherichia coli 0157:H7 on the films with different TiO2 contents that pre-coated on petri dishes. The experiments were carried out under fluorescent light irradiation. As shown in Figure 5, no significant changes in E. coli 0157:H7 populations were observed in the first three hours of irradiation, regardless of whether TiO2 powders were added or how they were added. A significant decrease in E. coli populations was observed after 18 h on TiO2/zein films. The cell numbers of E. coli inoculated on zein films (Sample #0) were less than those on non-coated petri dishes (controls), indicating E. coli suffered from growth on zein films as compared with the controls. It has been reported that zein films are resistant to bacterial attack [30]. The incorporation of TiO2 powders further suppressed bacterial growth. As the ratio of TiO2/zein increased from 0% (sample #0) to 1% (sample #1) and 2% (sample #2), the number of E. coli decreased 1 log successively. For the zein films with 10% TiO2 content (sample #3), no viable E. coli cells were detected (<1 log CFU/mL), indicating a bacteria-free surface created at high dose TiO2.

Figure 5.
Effect of TiO2 on growth of E. coli O157:H7. The bacterial populations on the surfaces of the films were determined after 3 (black colimn) and 18 h (white column) under FL irradiation. Control: no coating. Each tested Petri dish coated with 10 mL TiO2/zein formulation. The ratio of TiO2/zein in sample #0: 0 (neat zein); sample #1: 1%; sample #2: 2%; sample #3: 10%; sample #2+: double-layer film, 8 mL neat zein in bottom and 2 mL of sample #2 on top. Error bars represent the standard deviation of the mean. Data having a same uppercase (3 h) or lowercase (18 h) letter are not significantly different (p > 0.05). No viable E. coli cells were detected (<1 log CFU/mL) for samples #3 and #2+ at 18 h.
The antimicrobial activity of double-layer coating was then compared with the single-layer one. As shown in Figure 5, sample #2+ was a double-layer film with a neat zein layer in the bottom and a TiO2/zein layer on the top. The double-layer sample #2+ contained the same amount of TiO2 powders (2%) as sample #2 has, while the TiO2 content in the top layer was equal to that of entire sample #3 (10%). These results indicate the antibacterial activity of TiO2/zein films is determined by the amount of TiO2 embedded on the surfaces. For the double-layer films, the coating materials consist of a neat binder layer in bottom and another layer containing titanium dioxide powders on the top (Figure 1). While the more concentrated TiO2 powders on the top layer function more efficiently in deactivating microbes, the bottom layer, supposedly, should be able to facilitate the coating to anchor to the solid surfaces.
Florescent lamps are commonly used in warehouses and retail stores; they emit a narrow range of UV light (300–380 nm) in combination with a wide window of visible light (400–800 nm). Containers and shelves are usually exposed under visible light irradiation or UV irradiation for irregular time periods. To evaluate the effect of light irradiation on the antimicrobial activities of TiO2 coatings, Petri dishes coated with single-layer of 2% TiO2/zein were irradiated under two different conditions prior to antimicrobial test: one group was exposed to light for 15 h followed by placing in dark for 3 h; another group was exposed to light for 3 h followed by placing in dark for 15 h. The Petri dishes coated with doped-TiO2/zein formulation were included in the second group and tested in comparison with TiO2/zein coatings. As shown in Figure 6, sample #2 (group 1) had significantly lower E. coli populations than sample #2− (group 2 coated with TiO2/zein) after 18 h, indicating that longer time exposure to light enhanced the antimicrobial activity of the coatings. That could be attributed to the narrow UV window provided by the FL. However, sample #2++ (coated with codoped-TiO2/zein formulation) reduced much more E. coli cells than both sample #2 and sample #2−, and even sample #3 when compared under the same experimental conditions (Figure 5, black column). This could be attributed to the visible light irradiation that provides minimal energy to create electrons and promotes the electrons in the codoped-TiO2 to travel from valence band to the conduction band. The energy generated by visible light irradiation is not strong enough to activate pure TiO2 samples [31,32,33].

Figure 6.
Effect of light irradiation on growth of E. coli O157:H7 on zein/TiO2 coatings (2%). Sample #2: under light for 15 h and then in dark for 3 h; sample #2−: under light for 3 h and then in dark for 15 h; sample #2++: replacing TiO2 with codoped-TiO2, under light for 3 h and then at dark for 15 h. After 3 h (black column) and 18 h (white column) of irradiation, fractions were taken, processed for bacterial survival. Error bars represent the standard deviation of the mean.
Data shown in Figure 5 and Figure 6 indicated that the E. coli survival number was not significantly reduced after three hours of FL irradiation. Similar results were reported previously [34]. Probably, at the beginning of irradiation, the active species were generated, and UV deleterious effect began to attack the membrane but did not sufficiently overcome the self-defense and auto repair mechanisms of the species or cause serious damage to the bacteria to cause cell death; in this case, the injured bacterial cells can be recovered if enough nutrition supply is guaranteed. Under the longer irradiation, the anti-stress enzymes were no longer able to protect the bacterial membrane against oxidation; hence, the E. coli survival number decreased significantly.
Interestingly, codoped TiO2 coating (2++) showed more bacterial reduction than non-codoped TiO2 samples after 15 h in the dark (Figure 6). Wu et al. investigated the efficiency of photocatalytic inactivation E. coli under visible light irradiation using titanium dioxide nanoparticles codoped with N and Ag [35]. They also observed that the inactivation of E. coli in the dark after irradiation. It could be due to the biocidal properties of doped elements. The mechanism needs to be further investigated.
Figure 7 shows the residual E. coli cells on the films after washing. Sample #2+ had no colonies, Sample #2 had 11 colonies, Sample #2− had 140 colonies, and Sample #0 had over 300 colonies. It clearly demonstrated that the films coated with TiO2/zein did not only inhibit or reduce E. coli on their surfaces as shown in Figure 5 and Figure 6 but also increased the resistance to bacterial attachment and prevented biofilm forming on their surfaces.

Figure 7.
E. coli O157:H7 colonies on the surface of coated petri dishes after washing. Each petri dish coated with 10 mL zein formulations. (A) Sample #2+: bilayered film, 8 mL neat zein in bottom and 2 mL TiO2/zein (2%) on top (under light for 15 h and then in dark for 3 h); (B) Sample #2: TiO2/zein (2%, under light for 15 h and then in dark for 3 h); (C) Sample #2−: TiO2/zein (2%, under light for 3 h and then in dark for 15 h); (D) Sample #0: coating with neat zein (under light for 15 h and then in dark for 3 h).
Durability is another important consideration in coating material applications. We examined the durability of TiO2 coating using metal plate coated with TiO2/paint. Figure 8 shows the residual E. coli cells on the metal disks coated with a single layer TiO2/paint and washed 0 to 5 times. For samples exposed to light for 3 h (Figure 8a), there were no significant differences between controls (no coating) and coated samples without TiO2; both samples had 3–3.5 log CFU/mL E. coli cells on the surfaces. Samples coated with TiO2 had approximated 2 log CFU/mL, the coating reduced over 90% of E. coli on the disk surfaces regardless of the time length of water washing; for samples exposed to light for 18 h (Figure 8b), the residual E. coli cells were not detectable by the current method (<1.0 log CFU/mL) and achieved more than 99.7% reduction. Again, there were no significant differences observed for the antimicrobial activity among samples with different water-washing times.

Figure 8.
Survial of E. coli O157:H7 on the surface of metal disks. Sample disks under light for 3 h (a) and 18 h (b). No-coating: a disk wihout any coating; Control: coated disk without TiO2; CW0-5: Disk coated with codoped-TiO2 being washed in water for 0 to 5 times; *: under detetable level (<1.0 log/CFU); Error bars represent the standard deviation of the mean; Data having a common letter are not significantly different (p > 0.05).
4. Conclusions
We have developed a formulation consisting of zein or normal paint as binders embedded with titanium dioxide powders as active component. The two-step coating procedure allows more active titanium dioxide powders to concentrate on coating surfaces; thus, higher anti-microbial activity can be achieved. Containers and frameworks, either made from paper, or plastic, or metal coated with TiO2/zein (or TiO2/paint), especially with codoped-TiO2, are expected to be able to reduce the risk of the microbiological contamination of fruits and vegetables during harvest and postharvest; hence, they could be used in farms, food producers, warehouses, and retail-house.
Acknowledgments
The authors gratefully acknowledge the technical support of Joseph Uknalis.
Author Contributions
L.S.L. conceived and designed the experiments; R.L., T.Z.J., and Z.L. performed the experiments; R.L., T.Z.J., Z.L., and L.S.L. analyzed the data; R.L., T.Z.J., and L.S.L. wrote the paper.
Conflicts of Interest
The authors declare no conflict of interest.
References
- USDA Document. Available online: https://www.ers.usda.gov/data-products (accessed on 18 January 2018).
- Wells, H.F.; Buzby, J.C. Dietary Assessment of Major Trends in U.S. Food Consumption, 1970–2005; Economic Information Bulletin No. (EIB-33); U.S. Department of Agriculture Economic Research Service: Washington, DC, USA, 2008.
- USDA Document. Available online: https://www.choosemyplate.gov (accessed on 18 January 2018).
- Beuchat, L.R.; Nail, B.V.; Adler, B.B.; Clavero, M.R.S. Efficacy of spray application of chlorinated water in killing pathogenic bacteria on raw apples, tomatoes, and lettuce. J. Food Prot. 1998, 61, 1305–1311. [Google Scholar] [CrossRef]
- Outbreaks of Escherichia coli O157:H7 infection associated with drinking unpasteurized apple cider—October 1996. Update on emerging infections from the Center for Disease Control and Prevention. Ann. Emerg. Med. 1997, 29, 645–646.
- Lynch, M.F.R.; Tauxe, V.C.; Hedberg, W. The growing burden of foodborne outbreaks due to contaminated fresh produce: Risks and opportunities. Epidemiol. Infect. 2009, 137, 307–315. [Google Scholar] [CrossRef]
- Sapers, G.; Solomon, E.; Matthews, K.R. The Produce Contamination Problem: Causes and Solutions; Academy Press: Burlington, MA, USA, 2009. [Google Scholar]
- Langholz, J.A.; Jay-Russell, M.T. Potential role of wildlife in pathogenic contamination of fresh produce. Hum. Wildl. Interact. 2013, 7, 140–157. [Google Scholar]
- Augugliaro, V.; Bellardita, M.; Loddo, V.; Palmisano, G.; Palmisano, L.; Yurdakal, S. Overview on oxidation mechanism of organic compounds by TiO2 in heterogeneous photocatalysis. J. Photochem. Photobiol. C Photochem. Rev. 2012, 13, 224–245. [Google Scholar] [CrossRef]
- Pelaez, M.; Nolan, N.; Pillai, S.C.; Seery, M.K.; Falaras, P.; Kontos, A.G.; Dunlop, P.S.M.; Hamilton, J.W.J.; Byrne, J.A.; O’shea, K.; et al. A review on the visible light active titanium dioxide photocatalysts for environmental applications. Appl. Catal. B Environ. 2012, 15, 331–349. [Google Scholar] [CrossRef]
- Kedziora, A.; Trek, W.S.; Kepinski, L.; Bulga-Ploskonsa, G.; Doroszkiewicz, W. Synthesis and antibacterial activity of novel titanium dioxide doped with silver. J. Sol-Gel Sci. Technol. 2012, 62, 79–86. [Google Scholar] [CrossRef]
- Roy, A.; Parveen, A.; Koppalkar, A.R.; Prasad, A. Effect of nano-titanium dioxide with different antibiotics against methicillin-resistant Staphylococcus Aureus. J. Biomater. Nanotechnol. 2010, 1, 37–41. [Google Scholar] [CrossRef]
- Balek, V.; Li, D.; Šubrt, J.; Večerníková, E.; Hishita, S.; Mitsuhashi, T.; Haneda, H. Characterization of nitrogen and fluorine co-doped titania photocatalyst: Effect of temperature on microstructure and surface activity properties. J. Phys. Chem. Solids 2007, 68, 770–784. [Google Scholar] [CrossRef]
- Li, D.; Haneda, H.; Hishita, S.; Ohashi, N. Visible-light-driven N-F-Codoped TiO2 photocatalysts. I. synthesis by spray pyrolysis and surface characterization. Chem. Mater. 2005, 17, 2588–2595. [Google Scholar] [CrossRef]
- Im, J.S.; Yun, S.-M.; Lee, Y.-S. Investigation of multielemental catalysts based on decreasing the ban gap of titinia for enhanced visible light photocatalysis. J. Colloid Interface Sci. 2009, 336, 183–188. [Google Scholar] [CrossRef] [PubMed]
- Corradini, E.A.; de Medeiros, S.; Carvalho, E.; Curvelo, A.J.F.; Mattoso, H.L.C. Mechanical and morphological characterization of starch/zein blends plasticized with glycerol. J. Appl. Polym. Sci. 2006, 101, 4133–4139. [Google Scholar] [CrossRef]
- Parris, N.; Coffin, D.R. Composition factors affecting the water vapor permeability and tensile properties of hydrophilic zein films. J. Agric. Food Chem. 1997, 45, 1596–1599. [Google Scholar] [CrossRef]
- Lawton, J.W. Zein: A history of processing and use. Cereal Chem. 2002, 79, 1–18. [Google Scholar] [CrossRef]
- Liu, L.S.; Fishman, M.L.; Hicks, K.B.; Kende, M.; Ruthel, G. Pectin/Zein Beads for Potential Colon-Specific Drug Delivery: Synthesis and in vitro Evaluation. Drug Deliv. 2006, 13, 417–423. [Google Scholar] [CrossRef] [PubMed]
- Torres-Giner, S.; Gimenez, E.; Lagaron, J.M. Characterization of the morphology and thermal properties of zein prolamine nanostructures obtained by electrospinning. Food Hydrocoll. 2008, 22, 601–614. [Google Scholar] [CrossRef]
- Oh, Y.K.; Flanagan, D. Diffusional properties of zein membranes and matrices. Drug Dev. Ind. Pharm. 2010, 36, 497–507. [Google Scholar] [CrossRef] [PubMed]
- Zhang, B.; Luo, Y.; Wang, Q.A. Development of silver-zein composites as a promising antimicrobial agent. Biomacromolecules 2010, 11, 2366–2375. [Google Scholar] [CrossRef] [PubMed]
- Li, W.; Liu, L.S.; Jin, T.Z. Antimicrobial activity of allyl Isothiocyanate used to coat biodegradable composite films as affected by storage and handling conditions. J. Food Prot. 2012, 75, 2234–2237. [Google Scholar] [CrossRef] [PubMed]
- Chen, C.; Bai, H.; Chang, S.; Chang, C.; Den, W. Preparation of N-doped TiO2 photocatalyst by atmospheric pressure plasma process for VOCs decomposition under UV and visible light sources. J. Nanopart. Res. 2006, 9, 365–375. [Google Scholar] [CrossRef]
- Grey, I.E.; Li, C.; MacRae, C.M.; Bursill, L.A. Boron Incorporation into Rutile. Phase Equilibria and Structure Considerations. J. Solid State Chem. 1996, 127, 240–247. [Google Scholar] [CrossRef]
- Park, H.; Choi, W. Effects of TiO2 Surface Fluorination on Photocatalytic Reactions and Photoelectrochemical Behaviors. J. Phys. Chem. B 2004, 108, 4086–4093. [Google Scholar] [CrossRef]
- Giannakopoulou, T.; Todorova, N.; Trapalis, C.; Vaimakis, T. Effect of fluorine doping and SiO2 under-layer on the optical properties of TiO2 thin films. Mater. Lett. 2007, 61, 4474–4477. [Google Scholar] [CrossRef]
- Yu, J.; Zhao, X.; Zhao, Q.; Wang, G. Preparation and characterization of super-hydrophilic porous TiO2 coating films. Mater. Chem. Phys. 2001, 68, 253–259. [Google Scholar] [CrossRef]
- Mi, Y.Y.; Wang, S.J.; Chai, J.W.; Pan, J.S.; Huan, C.H.A.; Feng, Y.P. Effect of nitrogen doping on optical properties and electronic structures of SrTiO3 film. Appl. Phys. Lett. 2006, 89, 231922. [Google Scholar] [CrossRef]
- Serpone, N. Is the band gap of pristine TiO2 narrowed by anion- and cation-doping of titanium dioxide in second-generation photocatalysts? J. Phys. Chem. B 2006, 110, 24287–24293. [Google Scholar] [CrossRef] [PubMed]
- Zaleska, A. Doped-TiO2: A Review. Recent Pat. Eng. 2008, 2, 157–164. [Google Scholar] [CrossRef]
- Grabowska, E.; Reszczyńska, J.; Zaleska, A. Mechanism of phenol photodegradation in the presence of pure and modified-TiO2: A review. Water Res. 2012, 46, 5453–5471. [Google Scholar] [CrossRef] [PubMed]
- Liou, J.W.; Chang, H.H. Bactericidal effects and mechanisms of visible light-responsive titanium dioxide photocatalysts on pathogenic bacteria. Arch. Immunol. Ther. Exp. 2012, 60, 267–275. [Google Scholar] [CrossRef] [PubMed]
- Chen, F.; Yang, X.; Wu, Q. Photocatalytic Oxidation of Escherischia coli, Aspergillus niger, and Formaldehyde under Different Ultraviolet Irradiation Conditions. Environ. Sci. Technol. 2009, 43, 4606–4611. [Google Scholar] [CrossRef] [PubMed]
- Wu, P.; Xie, R.; Imlay, K.; Shang, J.K. Visible-Light-Induced Bactericidal Activity of Titanium Dioxide Codoped with Nitrogen and Silver. Environ. Sci. Technol. 2010, 44, 6992–6997. [Google Scholar] [CrossRef] [PubMed]
© 2018 by the authors. Licensee MDPI, Basel, Switzerland. This article is an open access article distributed under the terms and conditions of the Creative Commons Attribution (CC BY) license (http://creativecommons.org/licenses/by/4.0/).